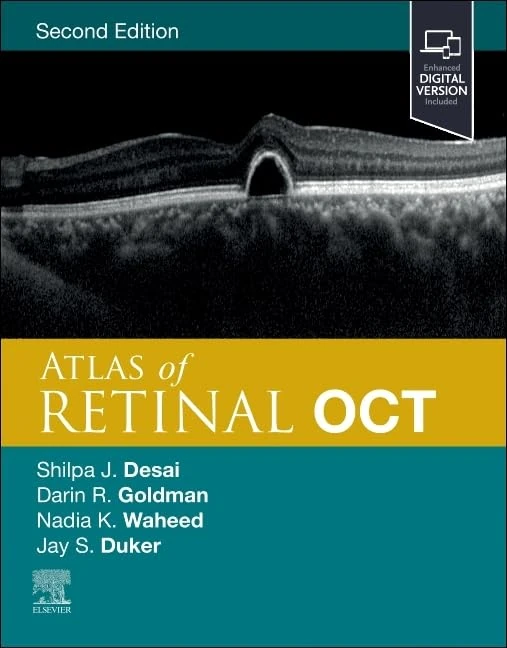
Atlas of Retinal OCT: Optical Coherence Tomography

Region:
Text search: "New Image"
Found 81 products
View product details

New Image Cyclone X3 Air Assault Exercise Bike - Unlimited Resistance Levels - LCD Display to Monitor RPM, Speed, Distance, Time & Calories Burned - Reinforced Steel Construction Design

New Image Cyclone X3 Air Assault Exercise Bike - Unlimited Resistance Levels - LCD Display to Monitor RPM, Speed, Distance, Time & Calories Burned - Reinforced Steel Construction Design
ASIN: B0B4S1W5P7
•
Brand: New Image
•
Amazon UK
£458.00
View product details

New Image FITT Gym - Pilates Reformer, Bodyweight Gym & Ab Trainer - MultiGym Total Body Fitness Home Workout Machine - Collapsible & Easy to Assemble - Adjustable Positioning

New Image FITT Gym - Pilates Reformer, Bodyweight Gym & Ab Trainer - MultiGym Total Body Fitness Home Workout Machine - Collapsible & Easy to Assemble - Adjustable Positioning
ASIN: B07VHR3FLC
•
Brand: New Image
•
Amazon UK
£179.00
View product details

New Image FITT Rider - Electromagnetic Indoor Exercise Bike - 16 Resistance Levels - Adjustable Seat & Comfort Grip Handlebars - LCD Display to Monitor Time, Distance, Speed & Calories

New Image FITT Rider - Electromagnetic Indoor Exercise Bike - 16 Resistance Levels - Adjustable Seat & Comfort Grip Handlebars - LCD Display to Monitor Time, Distance, Speed & Calories
ASIN: B0BS9NFX6J
•
Brand: High Street TV
•
Amazon UK
£399.99
View product details

New Image FITT Bell | Adjustable Water Kettle Bell Set | Exercise Fitness Weight Set | Weight Lifting | Core Training | Durable & Strong Design | Strength Training | Ultimate Core & Balance Workout

New Image FITT Bell | Adjustable Water Kettle Bell Set | Exercise Fitness Weight Set | Weight Lifting | Core Training | Durable & Strong Design | Strength Training | Ultimate Core & Balance Workout
ASIN: B09KV7CDSZ
•
Brand: New Image
•
Amazon UK
Currently out of stock
View product details

Invincible Volume 3 (New Edition)

Invincible Volume 3 (New Edition)
ASIN: 1534398090
•
Amazon UK
£11.00
View product details

Invincible Volume 1 (New Edition) (INVINCIBLE TP (NEW EDITION))

Invincible Volume 1 (New Edition) (INVINCIBLE TP (NEW EDITION))
ASIN: 153439995X
•
Amazon UK
£9.34
View product details

Invincible Volume 2 (New Edition) (INVINCIBLE TP (NEW EDITION))

Invincible Volume 2 (New Edition) (INVINCIBLE TP (NEW EDITION))
ASIN: 1534399038
•
Amazon UK
£10.99
View product details

Monstress Book Three (MONSTRESS HC)

Monstress Book Three (MONSTRESS HC)
ASIN: 1534335242
•
Brand: Image Comics
•
Amazon UK
£32.13
View product details

The Walking Dead Compendium Volume 1: 01 (WALKING DEAD COMPENDIUM TP)

The Walking Dead Compendium Volume 1: 01 (WALKING DEAD COMPENDIUM TP)
ASIN: 1607060760
•
Brand: Image Comics
•
Amazon UK
£37.99
View product details

Invincible Compendium Volume 2 (INVINCIBLE COMPENDIUM TP)

Invincible Compendium Volume 2 (INVINCIBLE COMPENDIUM TP)
ASIN: 1607067722
•
Brand: Image Comics
•
Amazon UK
£38.16
View product details

Invincible Universe Compendium Volume 1 (INVINCIBLE UNIVERSE COMPENDIUM TP)

Invincible Universe Compendium Volume 1 (INVINCIBLE UNIVERSE COMPENDIUM TP)
ASIN: 1534399968
•
Amazon UK
£26.75
View product details

Transformers Vol. 4: Conquer and Control

Transformers Vol. 4: Conquer and Control
ASIN: 1534332588
•
Brand: Image Comics
•
Amazon UK
£11.79
View product details

GPC Image TN2510XL TN2510 Toner Cartridge Compatible with Brother TN-2510XL, High Yield for Brother DCP-L2627DWE L2660DW; MFC-L2860DWE L2800DW L2860DW L2827DWXL L2827DW L2827DWE Printer, 1 x Black

GPC Image TN2510XL TN2510 Toner Cartridge Compatible with Brother TN-2510XL, High Yield for Brother DCP-L2627DWE L2660DW; MFC-L2860DWE L2800DW L2860DW L2827DWXL L2827DW L2827DWE Printer, 1 x Black
ASIN: B0CT5PQKQ9
•
Brand: GPC Image
•
Amazon UK
£18.56
View product details

GoPro HERO11 Black - Waterproof Action Camera with 5.3K60 Ultra HD Video, 27MP Photos, 1/1.9" Image Sensor, Live Streaming, Webcam, Stabilization

GoPro HERO11 Black - Waterproof Action Camera with 5.3K60 Ultra HD Video, 27MP Photos, 1/1.9" Image Sensor, Live Streaming, Webcam, Stabilization
ASIN: B0B9D6FD9R
•
Brand: GoPro
•
Amazon UK
Currently out of stock
View product details

GoPro HERO11 Black Bundle - Includes HERO11 Black Camera, Head Strap + QuickClip, and Enduro Battery (2 Total)

GoPro HERO11 Black Bundle - Includes HERO11 Black Camera, Head Strap + QuickClip, and Enduro Battery (2 Total)
ASIN: B0D1VY5VCG
•
Brand: GoPro
•
Amazon UK
£371.76
View product details

GoPro HERO11 Black Accessory Bundle - Includes Extra Enduro Battery (2 Total), The Handler (Floating Hand Grip), Headstrap + Quick Clip, and Carrying Case

GoPro HERO11 Black Accessory Bundle - Includes Extra Enduro Battery (2 Total), The Handler (Floating Hand Grip), Headstrap + Quick Clip, and Carrying Case
ASIN: B0BBP8N2MX
•
Brand: GoPro
•
Amazon UK
£369.99
View product details

Acc Art Books The Book of Rolex - Updated Revised Edition, New Images

Acc Art Books The Book of Rolex - Updated Revised Edition, New Images
ASIN: 178884310X
•
Brand: Acc Art Books
•
Amazon UK
£21.27
View product details

EBL AAA 1100mAh Ni-Mh Rechargeable Batteries, 10 Pack AAA Batteries with Storage Cases (New Packaging, Images Coming Soon)

EBL AAA 1100mAh Ni-Mh Rechargeable Batteries, 10 Pack AAA Batteries with Storage Cases (New Packaging, Images Coming Soon)
ASIN: B07W97W72R
•
Brand: EBL
•
Amazon UK
£9.99
View product details

EBL AA Rechargeable Batteries 2500mAh High Capacity Long Lasting Ni-MH Batteries 10 Packs (New Packaging, Images Coming Soon)

EBL AA Rechargeable Batteries 2500mAh High Capacity Long Lasting Ni-MH Batteries 10 Packs (New Packaging, Images Coming Soon)
ASIN: B088M1MQ2Q
•
Brand: EBL
•
Amazon UK
Currently out of stock
View product details

EBL 4 Pack 10000mAh D Size Rechargeable Batteries High Capacity Ni-MH D Batteries (New Packaging, Images Coming Soon)

EBL 4 Pack 10000mAh D Size Rechargeable Batteries High Capacity Ni-MH D Batteries (New Packaging, Images Coming Soon)
ASIN: B011RVEYHA
•
Brand: EBL
•
Amazon UK
£19.99
View product details

GoPro HERO11 Black Creator Edition - Includes HERO11 Black, Volta (Battery Grip, Tripod, Remote), Media Mod, Light Mod, Enduro Battery, and Carrying Case

GoPro HERO11 Black Creator Edition - Includes HERO11 Black, Volta (Battery Grip, Tripod, Remote), Media Mod, Light Mod, Enduro Battery, and Carrying Case
ASIN: B0BDM1CWQF
•
Brand: GoPro
•
Amazon UK
Currently out of stock
View product details

Webb, Müller and Naidich's High-Resolution CT of the Lung

Webb, Müller and Naidich's High-Resolution CT of the Lung
ASIN: 1975144430
•
Brand: Lippincott Williams & Wilkins
•
Amazon UK
£138.53
View product details

Manual of Canine and Feline Cardiology

Manual of Canine and Feline Cardiology
ASIN: 0323936598
•
Amazon UK
£95.27
View product details

Atlas of Retinal OCT: Optical Coherence Tomography
Atlas of Retinal OCT: Optical Coherence Tomography
ASIN: 0323930433
•
Amazon UK
£128.68
View product details

Sony Alpha 6400 | APS-C Mirrorless Camera

Sony Alpha 6400 | APS-C Mirrorless Camera
ASIN: B07MWDKNGN
•
Brand: Sony
•
Amazon UK
Currently out of stock
View product details

Sony Alpha 6400 | APS-C Mirrorless Camera with Sony 16-50 mm f/3.5-5.6 Power Zoom Lens

Sony Alpha 6400 | APS-C Mirrorless Camera with Sony 16-50 mm f/3.5-5.6 Power Zoom Lens
ASIN: B07MWDP1VD
•
Brand: Sony
•
Amazon UK
£799.00
View product details

Grainger & Allison's Diagnostic Radiology Essentials

Grainger & Allison's Diagnostic Radiology Essentials
ASIN: 0323936059
•
Amazon UK
£152.33
View product details

Ricoh GR IV plus Flash

Ricoh GR IV plus Flash
ASIN: B0FQJNGLRJ
•
Brand: Ricoh
•
Amazon UK
£1,299.98
View product details

Canon IXUS 285 HS Compact camera, 20.2 MP - Black

Canon IXUS 285 HS Compact camera, 20.2 MP - Black
ASIN: B01AI1IIRM
•
Brand: Canon
•
Amazon UK
£264.70
View product details

Sony SEL200600G High-Resolution Full Frame Super Telephoto Zoom G Lens with built in optical image stabilisation, SEL200600G.SYX & Alpha 7 III | Full-Frame Mirrorless Camera, Black

Sony SEL200600G High-Resolution Full Frame Super Telephoto Zoom G Lens with built in optical image stabilisation, SEL200600G.SYX & Alpha 7 III | Full-Frame Mirrorless Camera, Black
ASIN: B0BSBL79S2
•
Brand: Sony
•
Amazon UK
£2,494.00
View product details

Tamron - 20mm F/2.8 DI III OSD 1/2 - Macro lens for Sony FE - F050SF

Tamron - 20mm F/2.8 DI III OSD 1/2 - Macro lens for Sony FE - F050SF
ASIN: B07ZZHNXJH
•
Brand: TAMRON
•
Amazon UK
£199.00
View product details

KUSTOM ART Vintage Style Picture Picture Historical Image Workers Pausing On Hanging Cranes New York Collectible Print on Wood

KUSTOM ART Vintage Style Picture Picture Historical Image Workers Pausing On Hanging Cranes New York Collectible Print on Wood
ASIN: B09JZHVPGN
•
Brand: KUSTOM ART
•
Amazon UK
Currently out of stock
View product details

Sony DSCW830 Digital Compact Camera - Purple (20.1MP, 8x Optical Zoom) 2.7 Inch LCD

Sony DSCW830 Digital Compact Camera - Purple (20.1MP, 8x Optical Zoom) 2.7 Inch LCD
ASIN: B00HR3142G
•
Brand: Sony
•
Amazon UK
Currently out of stock
View product details

Thrall's Textbook of Veterinary Diagnostic Radiology

Thrall's Textbook of Veterinary Diagnostic Radiology
ASIN: 0323932355
•
Amazon UK
£107.92
View product details

GoPro HERO11 Black Camera - 5.3K60 Video, 24.7MP, Live Stream Renewed

GoPro HERO11 Black Camera - 5.3K60 Video, 24.7MP, Live Stream Renewed
ASIN: B0BRNVK36C
•
Brand: GoPro
•
Amazon UK
£239.99
View product details

Fujifilm FinePix S9200 Camera - Black (16.2MP, 50x Optical Zoom, CMOS Sensor)

Fujifilm FinePix S9200 Camera - Black (16.2MP, 50x Optical Zoom, CMOS Sensor)
ASIN: B00HXBRQME
•
Brand: Fujifilm
•
Amazon UK
£721.25
View product details

Nikon D3200 Digital SLR Camera with 18-55mm VR Lens Kit - Black (24.2MP) 3 inch LCD

Nikon D3200 Digital SLR Camera with 18-55mm VR Lens Kit - Black (24.2MP) 3 inch LCD
ASIN: B007VBGTX8
•
Brand: Nikon
•
Amazon UK
Currently out of stock
View product details

Ricoh GR III Diary Edition - 24MP APS-C Camera with 28mm f/2.8

Ricoh GR III Diary Edition - 24MP APS-C Camera with 28mm f/2.8
ASIN: B0C1HKVKQK
•
Brand: Ricoh
•
Amazon UK
£999.99
View product details

My First Advent Calendar: High Contrast Baby Book with Black and White Christmas Images to Develop Newborn Eyesight | Visual Stimulation gift for Infants (High Contrast Baby Books about Holidays)

My First Advent Calendar: High Contrast Baby Book with Black and White Christmas Images to Develop Newborn Eyesight | Visual Stimulation gift for Infants (High Contrast Baby Books about Holidays)
ASIN: B0DHCKK5RS
•
Amazon UK
£6.79
View product details

Tamron 18 - 400 mm f3.5-6.3 Di II VC HLD Lens for Canon - Black, B028E

Tamron 18 - 400 mm f3.5-6.3 Di II VC HLD Lens for Canon - Black, B028E
ASIN: B073361VDH
•
Brand: TAMRON
•
Amazon UK
Currently out of stock
View product details

Tamron B028N 18 - 400 mm f3.5-6.3 Di II VC HLD Lens for Nikon - Black

Tamron B028N 18 - 400 mm f3.5-6.3 Di II VC HLD Lens for Nikon - Black
ASIN: B07335VP63
•
Brand: TAMRON
•
Amazon UK
Currently out of stock
View product details

GoPro HERO11 Black Mini - Compact Waterproof Action Camera With 5.3K60 Ultra HD Video, 24.7MP Frame Grabs, 1/1.9" Image Sensor, Live Streaming, Stabilization

GoPro HERO11 Black Mini - Compact Waterproof Action Camera With 5.3K60 Ultra HD Video, 24.7MP Frame Grabs, 1/1.9" Image Sensor, Live Streaming, Stabilization
ASIN: B0BKNL3F92
•
Brand: GoPro
•
Amazon UK
£178.99
View product details

Canon PG-585XL / CL-586XL Genuine Ink Cartridges, Pack of 2 (1x Black, 1x Colour), Includes 50 Sheets of 4x6 Photo Paper - Compatible with PIXMA TS7650i / TS7750i

Canon PG-585XL / CL-586XL Genuine Ink Cartridges, Pack of 2 (1x Black, 1x Colour), Includes 50 Sheets of 4x6 Photo Paper - Compatible with PIXMA TS7650i / TS7750i
ASIN: B0DCBZDK6W
•
Brand: Canon
•
Amazon UK
£52.95
View product details

Leica 50mm f/1.4 Summilux-M Aspherical Manual Focus Lens (11892)

Leica 50mm f/1.4 Summilux-M Aspherical Manual Focus Lens (11892)
ASIN: B000U9EXT0
•
Brand: Leica
•
Amazon UK
Currently out of stock
View product details

101 Weekends in Europe, 2nd Edition (IMM Lifestyle Books) 160 Photos and Inspiration for Your Next Vacation Destination - the Best of Each City in Culture, Sights, Shopping, Accommodation, and Food

101 Weekends in Europe, 2nd Edition (IMM Lifestyle Books) 160 Photos and Inspiration for Your Next Vacation Destination - the Best of Each City in Culture, Sights, Shopping, Accommodation, and Food
ASIN: 1913618218
•
Amazon UK
£11.66
View product details

Canon PG-585 / CL-586 Genuine Ink Cartridges, Pack of 2 (1x Black, 1x Colour), Includes 50 Sheets of 4x6 Photo Paper - Compatible with PIXMA TS7650i / TS7750i

Canon PG-585 / CL-586 Genuine Ink Cartridges, Pack of 2 (1x Black, 1x Colour), Includes 50 Sheets of 4x6 Photo Paper - Compatible with PIXMA TS7650i / TS7750i
ASIN: B0DCBV9937
•
Brand: Canon
•
Amazon UK
£43.98
View product details

REVLON PROFESSIONAL Equave Hydro Bi-Phase Detangling Conditioner for Normal To Dry Hair, Leave-in Conditioner, Detangling Conditioner, Leave-in Conditioner with Heat Protection, Hair-Smoothing Leave-in Conditioner – 500 ml

REVLON PROFESSIONAL Equave Hydro Bi-Phase Detangling Conditioner for Normal To Dry Hair, Leave-in Conditioner, Detangling Conditioner, Leave-in Conditioner with Heat Protection, Hair-Smoothing Leave-in Conditioner – 500 ml
ASIN: B00CZCD63O
•
Brand: REVLON PROFESSIONAL
•
Amazon UK
£14.79
View product details

Adobe Photoshop Elements 2026 | 3-year term licence |1 Device|1 User|PC/MAC|Digital Download

Adobe Photoshop Elements 2026 | 3-year term licence |1 Device|1 User|PC/MAC|Digital Download
ASIN: B0FSHJB38X
•
Brand: Adobe
•
Amazon UK
£86.99
View product details

Sony Vlog camera ZV-1F | Digital Camera (Vari-angle Screen, 4K Video, slow motion, Vlog features) - Black (Renewed)

Sony Vlog camera ZV-1F | Digital Camera (Vari-angle Screen, 4K Video, slow motion, Vlog features) - Black (Renewed)
ASIN: B0CWLK2ZPF
•
Brand: Sony
•
Amazon UK
£399.00
View product details

Sony Vlog camera ZV-1F | Digital Camera (Vari-angle Screen, 4K Video, slow motion, Vlog features) - Black

Sony Vlog camera ZV-1F | Digital Camera (Vari-angle Screen, 4K Video, slow motion, Vlog features) - Black
ASIN: B0BHTWW59W
•
Brand: Sony
•
Amazon UK
£449.00
View product details

Samsung Galaxy S24, AI Android Smartphone, 8GB RAM, 256GB Storage, 50MP Camera, Long Battery Life, Amber Yellow, 3 Year Manufacturer Extended Warranty (UK Version)

Samsung Galaxy S24, AI Android Smartphone, 8GB RAM, 256GB Storage, 50MP Camera, Long Battery Life, Amber Yellow, 3 Year Manufacturer Extended Warranty (UK Version)
ASIN: B0CNTSGVLQ
•
Brand: Samsung
•
Amazon UK
£759.00
View product details

Samsung Galaxy S24, AI Android Smartphone, 8GB RAM, 128GB Storage, 50MP Camera, Long Battery Life, Amber Yellow, 3 Year Manufacturer Extended Warranty (UK Version)

Samsung Galaxy S24, AI Android Smartphone, 8GB RAM, 128GB Storage, 50MP Camera, Long Battery Life, Amber Yellow, 3 Year Manufacturer Extended Warranty (UK Version)
ASIN: B0CNTSTMGF
•
Brand: Samsung
•
Amazon UK
£699.00
View product details

All Dogs Have ADHD: An affirming introduction to ADHD

All Dogs Have ADHD: An affirming introduction to ADHD
ASIN: 1787756602
•
Brand: Jessica Kingsley Publishers
•
Amazon UK
£11.95
View product details

Sony CEB-G240T | CEB-G Series CFexpress Type B Memory Card

Sony CEB-G240T | CEB-G Series CFexpress Type B Memory Card
ASIN: B0CXJ3QK58
•
Brand: Sony
•
Amazon UK
£147.94
View product details

Canon Ink - PG-585XL Genuine High Yield Black Printer Ink Cartridge - Prints Up to 300 A4 Pages (1 x XL Cartridge) - Compatible PIXMA TS7650i / TS7750i

Canon Ink - PG-585XL Genuine High Yield Black Printer Ink Cartridge - Prints Up to 300 A4 Pages (1 x XL Cartridge) - Compatible PIXMA TS7650i / TS7750i
ASIN: B0CK75X759
•
Brand: Canon
•
Amazon UK
£25.49
View product details

Elizabeth Arden 5th Avenue Eau de Parfum Spray, 75ml, Fresh Floral Fragrance, Luxury Perfume for Women

Elizabeth Arden 5th Avenue Eau de Parfum Spray, 75ml, Fresh Floral Fragrance, Luxury Perfume for Women
ASIN: B0009OAI4U
•
Brand: Elizabeth Arden
•
Amazon UK
£19.50
View product details

Sony Alpha 7 III Full-Frame Mirrorless Camera (24.2MP, 4K Video, Fast 0.02s 693 Point Hybrid AF & 5 Axis stabilisation - Ideal for Enthusiasts, Hybrid Shooter and Low Light imaging)

Sony Alpha 7 III Full-Frame Mirrorless Camera (24.2MP, 4K Video, Fast 0.02s 693 Point Hybrid AF & 5 Axis stabilisation - Ideal for Enthusiasts, Hybrid Shooter and Low Light imaging)
ASIN: B07B4L1PQ8
•
Brand: Sony
•
Amazon UK
£969.00
View product details

Sony Alpha 7 III Full-Frame Mirrorless Camera with 28-70mm Lens (24.2MP, 4K Video, Fast 0.02s 693 Point Hybrid AF & 5 Axis stabilisation - Ideal for Enthusiasts, Hybrid Shooter and Low Light imaging)

Sony Alpha 7 III Full-Frame Mirrorless Camera with 28-70mm Lens (24.2MP, 4K Video, Fast 0.02s 693 Point Hybrid AF & 5 Axis stabilisation - Ideal for Enthusiasts, Hybrid Shooter and Low Light imaging)
ASIN: B07B4R8QGM
•
Brand: Sony
•
Amazon UK
£1,178.00
View product details

Cut Up This Book and Create Your Own Wonderland: 1,000 Unexpected Images for Collage Artists

Cut Up This Book and Create Your Own Wonderland: 1,000 Unexpected Images for Collage Artists
ASIN: 1837760020
•
Amazon UK
£12.68
View product details

Sony Alpha 7IV Full-Frame Mirrorless Camera (33MP, 4K 60p Video, Real- Time Eye AF, Fast Hybrid AF, Vari-Angle LCD, Wi-Fi, Bluetooth, for Hybrid shooters, Content Creators & Professional Photography)

Sony Alpha 7IV Full-Frame Mirrorless Camera (33MP, 4K 60p Video, Real- Time Eye AF, Fast Hybrid AF, Vari-Angle LCD, Wi-Fi, Bluetooth, for Hybrid shooters, Content Creators & Professional Photography)
ASIN: B09JPCB3WR
•
Brand: Sony
•
Amazon UK
£1,897.00
View product details

Sony Xperia 10 VII – 6.1" 19.5:9 OLED display with 120 Hz, 5,000 mAh battery, 16 mm ultra-wide-angle lens, 3.5 mm audio jack, Android 15, IP65/68, Dual SIM hybrid, Turquiose

Sony Xperia 10 VII – 6.1" 19.5:9 OLED display with 120 Hz, 5,000 mAh battery, 16 mm ultra-wide-angle lens, 3.5 mm audio jack, Android 15, IP65/68, Dual SIM hybrid, Turquiose
ASIN: B0FPDHCWXD
•
Brand: Sony
•
Amazon UK
£399.00
View product details

Sony Xperia 10 VII – 6.1" 19.5:9 OLED display with 120 Hz, 5,000 mAh battery, 16 mm ultra-wide-angle lens, 3.5 mm audio jack, Android 15, IP65/68, Dual SIM hybrid, Charcoal Black

Sony Xperia 10 VII – 6.1" 19.5:9 OLED display with 120 Hz, 5,000 mAh battery, 16 mm ultra-wide-angle lens, 3.5 mm audio jack, Android 15, IP65/68, Dual SIM hybrid, Charcoal Black
ASIN: B0FPDFGFLZ
•
Brand: Sony
•
Amazon UK
£390.00
View product details

Sigma 693955 50-100 mm F1.8 DC HSM Art Lens for Nikon Camera, Black

Sigma 693955 50-100 mm F1.8 DC HSM Art Lens for Nikon Camera, Black
ASIN: B01C3SCKIQ
•
Brand: Sigma
•
Amazon UK
£999.00
View product details

Sony Alpha 7IV Full-Frame Mirrorless Camera with 28-70mm Lens (33MP, 4K 60p Video, Real- Time Eye AF, Fast Hybrid AF, Vari-Angle LCD, for Hybrid shooters, Content Creators & Professional Photography)

Sony Alpha 7IV Full-Frame Mirrorless Camera with 28-70mm Lens (33MP, 4K 60p Video, Real- Time Eye AF, Fast Hybrid AF, Vari-Angle LCD, for Hybrid shooters, Content Creators & Professional Photography)
ASIN: B09JPCNS3X
•
Brand: Sony
•
Amazon UK
£2,149.00
View product details

Adobe Creative Cloud Pro | Student & Teacher | Graphic Design | AI Features | 1 Year| PC/Mac |Digital Download

Adobe Creative Cloud Pro | Student & Teacher | Graphic Design | AI Features | 1 Year| PC/Mac |Digital Download
ASIN: B00E3J2TPI
•
Brand: Adobe
•
Amazon UK
£114.99
View product details

Insta360 Ace Pro 2 Winter Bundle - 8K Waterproof Action Camera Co-Engineered with Leica, 1/1.3" Sensor, Dual AI Chip, Leading Low Light, Superior Audio, Flip Screen & AI Editing for Vlogs

Insta360 Ace Pro 2 Winter Bundle - 8K Waterproof Action Camera Co-Engineered with Leica, 1/1.3" Sensor, Dual AI Chip, Leading Low Light, Superior Audio, Flip Screen & AI Editing for Vlogs
ASIN: B0F4K7YZ28
•
Brand: Insta360
•
Amazon UK
Currently out of stock
View product details

Insta360 Ace Pro 2 Motorcycle Bundle - 8K Waterproof Action Camera Co-Engineered with Leica, 1/1.3" Sensor, Dual AI Chip, Leading Low Light, Superior Audio, Flip Screen & AI Editing for Vlogs

Insta360 Ace Pro 2 Motorcycle Bundle - 8K Waterproof Action Camera Co-Engineered with Leica, 1/1.3" Sensor, Dual AI Chip, Leading Low Light, Superior Audio, Flip Screen & AI Editing for Vlogs
ASIN: B0DKBSNFVH
•
Brand: Insta360
•
Amazon UK
Currently out of stock
View product details
![Fania Records: The Latin Sound Of New York (1964-1978) [VINYL]](/uploads/images/products/2/B0DMWSH4SD/094f1842-626f-4c60-b6c7-18d9c01637b7.webp)
Fania Records: The Latin Sound Of New York (1964-1978) [VINYL]
![Fania Records: The Latin Sound Of New York (1964-1978) [VINYL]](/uploads/images/products/2/B0DMWSH4SD/094f1842-626f-4c60-b6c7-18d9c01637b7.webp)
Fania Records: The Latin Sound Of New York (1964-1978) [VINYL]
ASIN: B0DMWSH4SD
•
Brand: Craft Recordings
•
Amazon UK
£33.44
View product details
![Corel PaintShop Pro 2023 | Photo Editing & Graphic Design Software | AI Powered Features | Standard | 1 Device | 1 User | PC | Code [Delivery]](/uploads/images/products/2/B0B8P83ZW7/cb68d816-e826-4342-a779-5ca1f1d10ca8.webp)
Corel PaintShop Pro 2023 | Photo Editing & Graphic Design Software | AI Powered Features | Standard | 1 Device | 1 User | PC | Code [Delivery]
![Corel PaintShop Pro 2023 | Photo Editing & Graphic Design Software | AI Powered Features | Standard | 1 Device | 1 User | PC | Code [Delivery]](/uploads/images/products/2/B0B8P83ZW7/cb68d816-e826-4342-a779-5ca1f1d10ca8.webp)
Corel PaintShop Pro 2023 | Photo Editing & Graphic Design Software | AI Powered Features | Standard | 1 Device | 1 User | PC | Code [Delivery]
ASIN: B0B8P83ZW7
•
Brand: Corel
•
Amazon UK
£38.61
View product details

2026 CALENDAR MRS BROWN'S BOYS MONTH TO VIEW SQUARE WALL CALENDAR OFFICIAL PRODUCT

2026 CALENDAR MRS BROWN'S BOYS MONTH TO VIEW SQUARE WALL CALENDAR OFFICIAL PRODUCT
ASIN: 1835274668
•
Brand: Danilo Promotions LTD
•
Amazon UK
£10.94
View product details
![Brat and it’s completely different but also still brat (Brat Green 2LP Vinyl) [VINYL]](/uploads/images/products/2/B0DTTTWNFN/c039e24c-8bcd-41af-aba1-f713ce98c90f.webp)
Brat and it’s completely different but also still brat (Brat Green 2LP Vinyl) [VINYL]
![Brat and it’s completely different but also still brat (Brat Green 2LP Vinyl) [VINYL]](/uploads/images/products/2/B0DTTTWNFN/c039e24c-8bcd-41af-aba1-f713ce98c90f.webp)
Brat and it’s completely different but also still brat (Brat Green 2LP Vinyl) [VINYL]
ASIN: B0DTTTWNFN
•
Brand: Atlantic
•
Amazon UK
£42.29
View product details

Apple iPad Air 2 Tablet-PC (Space Grey) - (A1567 Processor, 128 GB HDD, Mac OS 9.X) (Renewed)

Apple iPad Air 2 Tablet-PC (Space Grey) - (A1567 Processor, 128 GB HDD, Mac OS 9.X) (Renewed)
ASIN: B00P7C038K
•
Brand: Apple
•
Amazon UK
£149.99
View product details

Textbook of Radiographic Positioning and Related Anatomy

Textbook of Radiographic Positioning and Related Anatomy
ASIN: 032393613X
•
Amazon UK
£156.28
View product details

Fujifilm X100V Digital Camera - Black

Fujifilm X100V Digital Camera - Black
ASIN: B084B3Z8FX
•
Brand: Fujifilm
•
Amazon UK
Currently out of stock
View product details

Leica 40318 Trinovid 8X42 HD Binoculars

Leica 40318 Trinovid 8X42 HD Binoculars
ASIN: B01BLFHYEW
•
Brand: Leica
•
Amazon UK
£1,009.12
View product details

Scream From New York, NY

Scream From New York, NY
ASIN: B0CX2MMYP6
•
Brand: UNIVERSAL MUSIC GROUP
•
Amazon UK
£11.99
View product details
![Scream From New York, NY [VINYL]](/uploads/images/products/2/B0CX2W44KC/7aa042ed-16e0-48ce-9f4c-0e86d3e5dc03.webp)
Scream From New York, NY [VINYL]
![Scream From New York, NY [VINYL]](/uploads/images/products/2/B0CX2W44KC/7aa042ed-16e0-48ce-9f4c-0e86d3e5dc03.webp)
Scream From New York, NY [VINYL]
ASIN: B0CX2W44KC
•
Brand: Virgin Music
•
Amazon UK
£22.69
View product details

Adobe Creative Cloud 1TB :Photoshop&Lightroom |1 Year| PC/Mac | Digital Download

Adobe Creative Cloud 1TB :Photoshop&Lightroom |1 Year| PC/Mac | Digital Download
ASIN: B076JV1L5H
•
Brand: Adobe
•
Amazon UK
£98.99
View product details

PENTAX K-1 Mark II Digital SLR Camera Body: 36.4MP Full Frame High Resolution Digital Camera 5 axis, 5 steps Shake Reduction II Weather-resistant construction Dustproof Flexible Tilt-Type LCD monitor

PENTAX K-1 Mark II Digital SLR Camera Body: 36.4MP Full Frame High Resolution Digital Camera 5 axis, 5 steps Shake Reduction II Weather-resistant construction Dustproof Flexible Tilt-Type LCD monitor
ASIN: B079X2QJ3Y
•
Brand: Pentax
•
Amazon UK
£1,449.00
View product details

Canon RF 50mm F1.2L USM Lens - L-series Prime Lens | Weatherproof | High Low-Light Performance | Portrait, Weddings, Street Photography | Canon EOS R Compatible

Canon RF 50mm F1.2L USM Lens - L-series Prime Lens | Weatherproof | High Low-Light Performance | Portrait, Weddings, Street Photography | Canon EOS R Compatible
ASIN: B07H946LG6
•
Brand: Canon
•
Amazon UK
£1,849.63
View product details

Insta360 Ace Pro 2 Xplorer Bundle Moonlight Silver - 8K Waterproof Action Camera Co-Engineered with Leica, 1/1.3" Sensor, Dual AI Chip, Leading Low Light, Street Photography, Dual Battery

Insta360 Ace Pro 2 Xplorer Bundle Moonlight Silver - 8K Waterproof Action Camera Co-Engineered with Leica, 1/1.3" Sensor, Dual AI Chip, Leading Low Light, Street Photography, Dual Battery
ASIN: B0FG35XB2X
•
Brand: Insta360
•
Amazon UK
£469.99